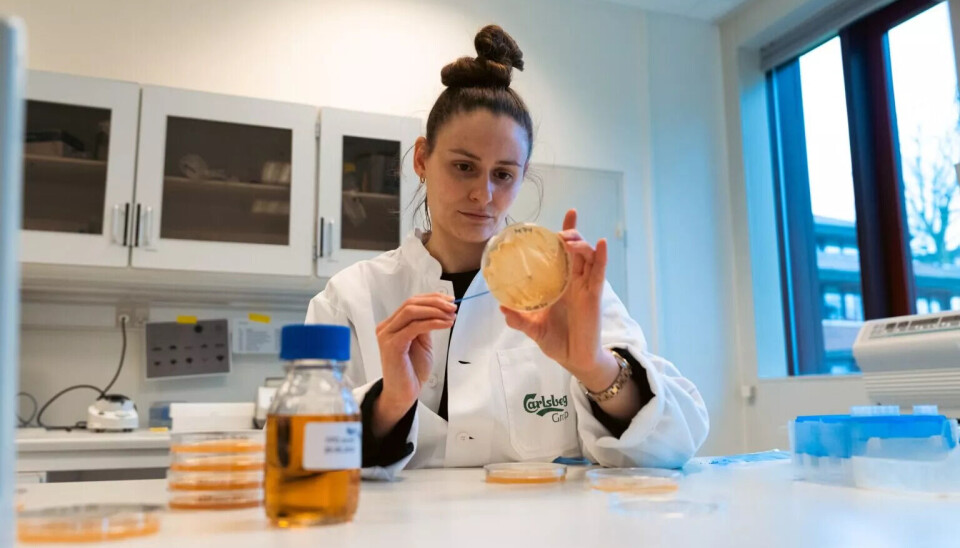

Noen beskriver det som et våpenkappløp.
Andre kaller det en entusiastisk idéutvikling der forskere inspirerer hverandre til å lage gode, alkoholfrie øl med nye metoder.
Bare hos Carlsberg bryggeri i Danmark jobber rundt 100 forskere med å finne opp nye produkter. Mange av dem forsker på alkoholfrie produkter. Det er mye penger å tjene for det bryggeriet som klarer å finne opp noe originalt og godt.
Bryggmester Erik Lund hos Carlsberg Laboratoriet viser den danske forskningsavisen Videnskab.dk rundt i testlokalene på Frederiksberg, utenfor København.
– I dag er det mange flere situasjoner der folk foretrekker alkoholfritt øl enn det var i gamle dager. Den virkeligheten tilpasser vi oss selvfølgelig ved å prøve å lage de mest velsmakende produktene, sier Lund.
Bare i første kvartal av 2025 har Carlsbergs salg av alkoholfritt øl økt med 15 prosent. Det er en markant økning i forhold til salget av tradisjonelt øl, mener forskningslederen.
Carlsberg er ikke alene om å oppleve økt salg. Hos bryggerier og på universiteter er det flere og flere forskere jobber med å finne det perfekte alkoholfrie ølet.
Veien videre fra den destillerte pilsen
Markedet er fortsatt dominert av øl laget på gamlemåten: Avdamping av alkohol, også kalt dealkoholisering.
Det forteller Kim Lou Johansen, bryggmester og sjefrådgiver ved Institut for Fødevarevidenskab ved Københavns Universitet. Han sier det er komplisert å lage øl som ikke skal gi rus.
– Alkohol bidrar med munnfølelse og fylde, smak og aroma, så det å droppe alkoholen gjør ølbryggingen vanskeligere, sier han.
– Vanligvis lager man en tradisjonell pilsner med alkohol i, og så varmer man den opp under vakuum til alkoholen er fordampet, forteller han.
– Men hvis man fjerner alkohol ved å varme noe opp og få det til å fordampe, så risikerer man også at noen andre ting fordamper i prosessen. Så man er nødt til å gjøre noen triks for å bevare en god smak, sier Johansen.
Han peker på at mange store bryggerier tilsetter andre ingredienser etter avdampingen, slik som i Carlsberg Nordic, Tuborg Nul, 1664 Blanc 0,0, Heineken 0,0 og Royal Pilsner 0,0.

I Carlsbergs laboratorium på Frederiksberg finner forskere nye ingredienser til alkoholfritt øl. Her er det en ny og mer bærekraftig type bygg som skal brukes til ølbrygging. (Foto: Daniel Rasmussen)
Alkoholfritt øl skal være mer bærekraftig
En annen utfordring ved avdamping er bærekraft. Det er allerede brukt energi på å lage et tradisjonelt øl. Så skal det brukes ekstra energi på å varme det opp igjen for å fjerne alkoholen.
Nettopp derfor jobber mange forskere med alternativer til avdamping. I en italiensk studie fra 2025 beskrives to andre metoder for å fjerne alkohol fra øl:
- Nanofiltrering
- Omvendt osmose
I metodene filtreres ølet gjennom en membran, en slags bitte liten sil, hvor små molekyler – som alkohol og vann – slipper igjennom. De store smaksmolekylene, som sukker, proteiner og aromaer, blir holdt tilbake.
Problemet er at også disse metodene kan skade smaken eller fylden. Ifølge en annen dansk ølforsker er det derfor annen forskning som er mer interessant.
Kaldgjæring med tradisjonelle gjærtyper
– Min tilnærming til alkoholfritt øl er litt som til veganermat, sier Mikkel Hansen.
Han er bryggingeniør og postdoc ved DTU Fødevareinstituttet, hvor han underviser og forsker på ølbrygging.
– I stedet for å prøve å få noe til å smake som en rett med kjøtt - det vil uansett aldri bli like godt - så synes jeg man skal lage noe nytt i en kategori for seg: Alkoholfritt øl som smaker godt på sine egne premisser.
Ett alternativ til å fjerne alkoholen fra ølet er en metode kalt kaldgjæring eller cold contact.
Det er gjæringen som skaper alkoholen i et øl. Men ved å gjøre gjæringen kaldere, og dermed langsommere, kan alkoholen holdes nede.
De 5 hovedfasene i ølbrygging
- Mesking: Tenk på det som å lage en stor gryte søt grøt. Du tar knust malt – som er spiret og tørket korn, oftest bygg – og blander det med varmt vann. Varmen aktiverer enzymer som lager stivelsen i kornet om til sukker. Sukkeret er viktig, for det er dette gjæren senere spiser og lager om til alkohol. Etter hvert får du en søt væske, kalt vørter.
- Filtrering: Kornrestene skilles fra vørteren. Det er som å helle grøt gjennom en sil og bare ta vare på den søte væsken.
- Koking: Vørteren blir kokt, og det tilsettes humle – planten som gir øl bitterhet og aroma. Det er også her eventuelle bakterier blir drept, slik at ølet blir rent.
- Gjæring (fermentering): Når vørteren er kjølt ned, tilsettes gjær. Og nå skjer magien: Gjæren spiser sukkeret og gjør det om til alkohol og kullsyre. Det tar vanligvis en til to uker, men noen øltyper skal gjære i månedsvis.
- Modning og tapping: Til slutt skal ølet stå litt og sette seg, så smaken blir rund og god. Det meste ølet fra de store bryggeriene blir filtrert. Så helles det på flasker, bokser eller fat. Noen ganger tilsettes litt ekstra sukker eller kullsyre.
Kilder: DTU/Københavns Universitet/Carlsberg
Hos Erik Lund i Carlsberg står et øl på bordet: «Special Effects» fra bryggeriet Brooklyn som Carlsberg har kjøpt retten til å brygge.
Dette er et øl laget gjennom kaldgjæring. Ifølge Lund er prosessen som å styre en racerbil, fordi gjæren som brukes, er den samme som brukes til alkoholholdig øl.
– Når man putter en racerbil ned i vørteren (ølets første fase under ølbryggingen - se faktaboksen ovenfor, red.anm.) og vil ha den til å kjøre sakte, så handler det om å ikke skru temperaturen for mye opp. Man er nødt til å ta høyde for at gjæren normalt ville gitt en alkoholprosent på 4 til 7 prosent, sier han.
Søtlig smak
Kaldgjæring av alkoholfritt øl foregår oftest ved rundt 0 til 2 grader. Når bryggeriene lager annet øl, er temperaturen 12 til 16 grader. At det er kaldere, gjør at gjæren blir tregere til å omdanne maltose fra vørteren til alkohol, forteller Lund.
Fordelene ved kaldgjæring er at det er enkelt og billig. Ulempen er at det går saktere og at ølet kan få ganske søtlig smak, fordi bare en liten del av sukkeret i vørteren gjæres til alkohol. Gjæren rekker heller ikke å danne samme mengde syre.
– Derfor prøver mange som bruker cold contact-metoden å kompensere for sødmen og den manglende syren ved å tilføye ekstra humle, forteller Lund.
Han tar en slurk av «Special Effects»-ølet.
– Jeg synes fortsatt man kan smake sødmen, men fordi den er ganske bitter og tørrhumlet, får man et ganske harmonisk øl.
Nye gjærtyper som ikke danner alkohol
Carlsberg og forskere fra andre bryggerier og universiteter gjør også noe helt nytt.
De utvikler og tester nye gjærtyper som ikke produserer alkohol – eller bare veldig lite av det.
Fordelen ved den typen gjær er at den danner smak i samme tempo som de tradisjonelle gjærtypene. Det er bra med tanke på bærekraft, fordi det går raskere enn kaldgjæring. Samtidig blir det skapt masse aroma og alkohollignende munnfølelse og fylde.
Carlsberg Laboratorium har rundt 100 forskere som utvikler nye øl, blant annet ved å finne frem til nye gjærtyper som ikke produserer alkohol under gjæring. (Foto: Daniel Rasmussen)
Det danske firmaet Novonesis står bak gjærtypen med det latinske navnet Pichia kluyveri. Den egner seg godt til å lage alkoholfritt øl, ifølge en studie fra Københavns Universitet i 2024. Gjærtypen brukes allerede av mellomstore danske bryggerier som To øl og Mikkeller.
Pichia kluyveri gjør ikke maltose om til alkohol. En egenskap som mange andre forskere også leter etter, fordi maltose er den mest dominerende sukkerarten i vørter.
Erik Lund hos Carlsberg sier også at denne typen gjær er lovende, mens han viser vei inn i en av laboratoriets litt mer hemmelige avdelinger: selve bryggeriet.
Bryggmesteren forteller at det er her de prøver nye ingredienser og metoder. Han peker på en tank på 50 liter hvor en ny gjærtype er i gang med å fermentere en vørter - uten å lage alkohol.
– Hvis denne tanken hadde inneholdt vanlig gjær fra et Carlsberg-Tuborg-øl, ville gjæren akkurat nå ha spist så mye sukker den kunne. Men det gjør ikke denne gjæren, sier han og leser på lappen som henger på tanken.
«IBIZA», står det på den.
– «I Believe In Zero Alcohol», forklarer Erik Lund om navnet på forskningsprosjektet.
Men han vil ikke ut med navnet på gjæren, siden de ikke er ferdige med å teste smak og bryggeprosess.
Kilde:
Applications of Reverse Osmosis and Nanofiltration Membrane Process in Wine and Beer Industry, Membranes (2025), DOI: 10.3390/membranes15050140
© Videnskab.dk. Oversatt og redigert av Trine Andreassen for forskning.no. Les originalsaken på videnskab.dk her.


Opptatt av hva som
skjer i samfunnet?
Utdanning, familie, økonomi, politikk og ledelse er bare noe av det du blir oppdatert på i nyhetsbrev fra forskning.no.